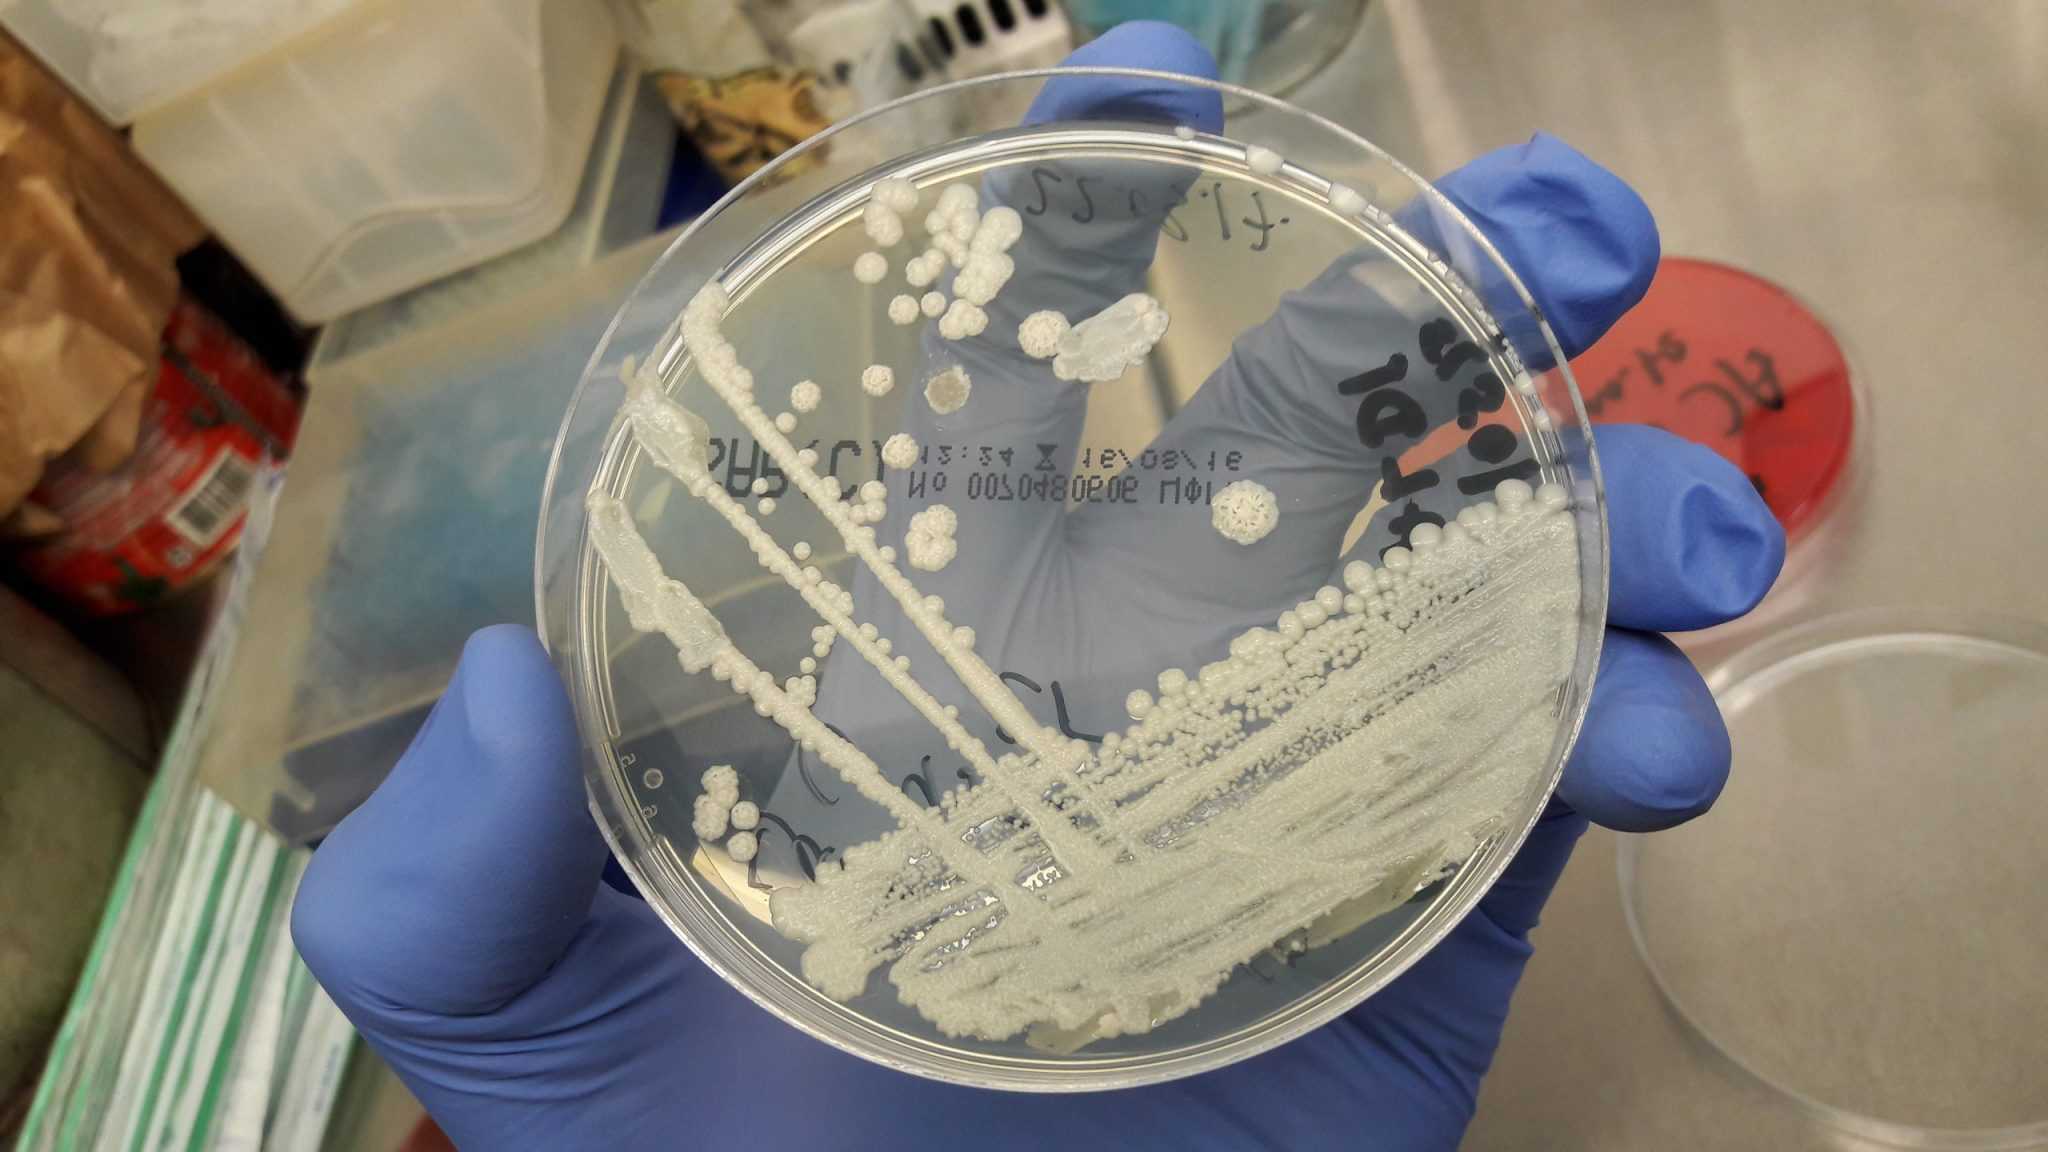

Если Вам нужен способ лечения вагинальной дрожжевой инфекции, у меня есть несколько отличных советов на этот счёт. Дрожжи любят расти в тёплой влажной среде, и влагалище — лучшее место для этого на Вашем теле. Звучит грубовато, но это правда. Есть несколько шагов, которые Вы можете предпринять для предотвращения развития дрожжевой инфекции; а на случай, если инфекция уже есть, существует также несколько методов ее эффективного лечения.
Грибковые инфекции вызываются микроорганизмами Candida Albicans или Monilia, которые могут начать размножаться на любом участке тела, и даже попасть в кровоток. В обычных условиях они не несут угрозы заражения, но если вследствие каких-то действий или даже употребления определённых продуктов в организме меняется РН-баланс, вероятность развития инфекции растёт.
Лучший метод лечения молочницы влагалища заключается в противогрибковых кремах или суппозиториях, вводимых непосредственно во влагалище. Вы можете самостоятельно регулировать продолжительность лечения, выбрав курс суппозиториев, рассчитанный на один день, три дня или семь дней. Вводить крем мом суппозитории нужно на ночь, перед сном, в положении лежа, чтобы лекарство попало на нужный участок и не выводилось обратно под действием силы тяжести.
Честно говоря, в случае дрожжевой инфекции все наверняка хотят избавиться от неё как можно быстрее, поэтому лучшим выбором мне кажется курс лечения, рассчитанный на однократное применение. Оно того стоит – ведь Вы сможете почувствовать облегчение уже на следующий день. Единственное, что может Вас побеспокоить – выделения в течение нескольких следующих дней. Просто воспользуйтесь тонкой прокладкой, и это не составит особой проблемы. Кроме того, можно поддерживать чистоту и свежесть в течение дня с помощью вагинальных очищающих салфеток.
Чтобы поддерживать нормальный РН-баланс вагинальной области, не злоупотребляйте спринцеваниями. Старайтесь есть йогурт каждый день, особенно те формы, которые содержат пробиотики. Пробиотики помогут сохранить РН-баланс в порядке, снижая тем самым вероятность дрожжевых инфекций.
Один из путей предотвращения дрожжевых инфекций – никогда не надевать обтягивающую одежду и носить только хлопковое бельё. Обеспечьте доступ воздуха к вагинальной области и не носите нейлоновые чулки или колготки каждый день. Не пользуйтесь женскими спреями или тальком. Для уверенности в сухости паховой области после ванны или душа можно воспользоваться феном на минимальной мощности.
Не пользуйтесь ароматизированной туалетной бумагой, гигиеническими салфетками или тампонами. Избегайте любых «дезодорирующих» средств. В периоды менструаций носите с собой побольше прокладок/тампонов, чтобы чаще менять их, и не забывайте тщательно подмываться при каждой замене, чтобы не создавать дрожжевому грибку условий для роста. И тогда Вам не понадобятся советы для лечения молочницы!